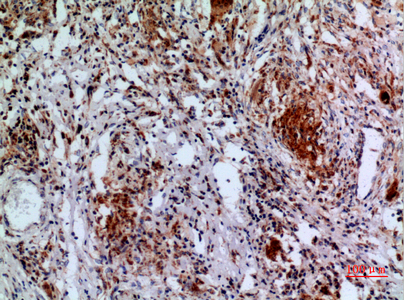

Anti-APAF1 Antibody
A97715
ApplicationsWestern Blot, ELISA
Product group Antibodies
ReactivityHuman, Mouse, Rat
Overview
- SupplierAntibodies.com
- Product NameAnti-APAF1 Antibody
- Delivery Days Customer7
- ApplicationsWestern Blot, ELISA
- CertificationResearch Use Only
- ClonalityPolyclonal
- ConjugateUnconjugated
- HostRabbit
- IsotypeIgG
- Scientific DescriptionRabbit polyclonal antibody to APAF1.
- ReactivityHuman, Mouse, Rat
- UNSPSC12352203

![APAF1 antibody [C3], C-term detects APAF1 protein at cytoplasm in rat liver by immunohistochemical analysis. Sample: Paraffin-embedded rat liver. APAF1 antibody [C3], C-term (GTX101067) diluted at 1:400.
Antigen Retrieval: Citrate buffer, pH 6.0, 15 min](https://www.genetex.com/upload/website/prouct_img/normal/GTX101067/GTX101067_40359_20160713_IHC-P_R_w_23060100_579.webp)

